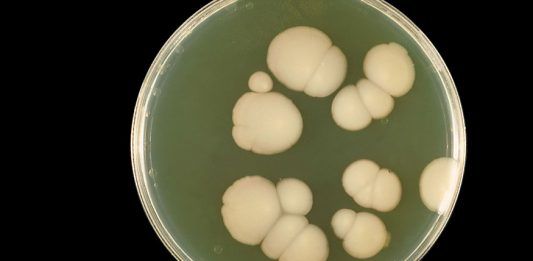
Candida auris

Candida auris: un hongo resistente a medicamentos está causando preocupación en el mundo
Las alarmas están saltando en Estados Unidos y en muchas partes del mundo con una nueva enfermedad que asola a las personas cuyo sistema inmunitario es deficiente. Se trata de la infección por Candida auris, un hongo que presenta una resistencia increíble a medicamentos dirigidos usualmente a los microorganismos de su especie. Recientemente se ha … Sigue leyendo Candida auris: un hongo resistente a medicamentos está causando preocupación en el mundo